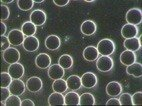

DETOX | NUTRITION | LIFESTYLE
Research-led Health Science and Clinical Investigation
Live Blood Analysis
Blood is the vital fluid of life within us and the tissue most easily monitored to show rapid changes in response to diet changes, nutrients, pH, hydration, electromagnetic frequencies, emotions, and toxic interventions.
One drop of blood reveals the size, shape and ratios of the red cells, white cells, platelets and plasma of your blood. Nothing compares to seeing your own 'live' or 'active' blood on a screen.
This is not to be confused with traditional laboratory blood testing, which isn't carried out in a live fashion.
Together, Live Blood Analysis and Dry Blood Analysis yields a comprehensive health overview. Live blood analysis focuses on cellular morphology, while Dry Blood Analysis looks at coagulation morphology, offering a multi-dimensional perspective. This dual approach enhances anomaly detection precision and provides a nuanced interpretation of overall health. By opting for both analyses, you gain a thorough and insightful assessment, empowering proactive health management.
WHAT IS LIVE BLOOD CELL ANALYSIS?
Technically referred to as Darkfield Microscope Wet-Mount Examination of a Peripheral Blood Smear
Live blood analysis involves visual examination of a small droplet of capillary blood from the fingertip. The blood is put on a glass slide and observed under a high-powered light microscope, typically dark-field. This method offers a qualitative visual perspective of the blood cells and plasma, known as the “biological terrain” in integrative healthcare, which supports and sustains the cells and their vitality.
Live blood cell analysis does not diagnose or determine pathologies.
It simply observes various components of your blood and determines how functional or optimal your blood system is working.
Analysis can reveal numerous conditions, including the stickiness of red blood cells (RBCs) and their tendency to aggregate and clot, as well as the formation of fibrin—the chief clotting protein—and aggregation of platelets. The presence or absence of these clotting factors can be readily seen using dark-field live blood analysis. Early blood clotting has been linked to chronic systemic biochemical inflammation, which is at the root of chronic disease.
Human blood is composed of 45% cellular components and 55% plasma. Blood has many functions, including transporting oxygen, regulating body temperature, and supporting the immune system.
The cellular component consists of three major cell types: red blood cells (RBCs), white blood cells (WBCs), and platelets.
Red blood cells (RBC, erythrocytes) are hemoglobin carrying cells that primarily transport and deliver oxygen and nutrients to every cell in the body, picking up carbon dioxide and waste products for delivery to the organs of elimination.
White blood cells (WBC, leukocytes) take the form of either granulocytes or lymphocytes. Granulocytes are part of the innate immune system and play a key role in the immune response to bacteria, fungi, and parasites. Lymphocytes are highly antigen-specific, meaning they are able to target specific infectious agents, primarily viruses.
Platelets are the other major cellular component of blood and are small cells, that help blood clot.
HOW IS THE TEST PERFORMED?
The test itself is quite simple.
Using a tiny, non-invasive, pin prick needle on the finger tip, a small fresh drop of living capillary blood is taken and placed directly on a glass microscope slide.
Without fixation or colouring, the living blood is is covered with a glass cover and placed under a high powered darkfield microscope for immediate examination, up to 1000x magnification.
The sample is illuminated in a way that makes the minutest detail visible.
The image is transmitted onto a monitor for the client and practitioner to view simultaneously.
The examination lasts approximately 25 minutes.
Seeing is believing
The condition of our blood is of paramount importance to the state of our health and can be a reflection of many factors including diet and lifestyle choices.
Live blood analysis lets you see your blood and allows you to take a real part in your healthcare.
Your blood picture, known as your terrain, may help you better understand the effects of diet, lifestyle and environmental conditions on your health.
You will be able to view the various components of your blood such as the size, shape, associations, ratios and fine structure of the red blood cells, various types of white blood cells, platelets and blood plasma, as they function in the body.
Making improvements to your diet and lifestyle can not only help you achieve better health, these achievements can be visible in your overall blood picture.
WHAT ARE THE ADVANTAGES?
Nothing compares to seeing your own 'live' and 'active' blood on a screen..
The immediacy of live blood analysis means that blood parameters can be seen in real time, no waiting for results.
Re-examinations allow updating and fine tuning of your health-care program so that there will be continuous improvement.
Improvements help you to feel better, look better, and perform better.
CHOOSE LEAN, CLEAN WHOLE FOODS TO IMPROVE YOUR HEALTH...
In the 21st century much of our food is highly processed and contains many artificial additives, sugars, hydrogenated oils and trans fats, high salt, low fibre, etc. These foods can create imbalances and compromise our health.
Consciously choosing a lean, clean diet from organically grown and farm reared sources, whole foods, variety of fruits and vegetables the colours of the rainbow and regularly supplementing with certain nutrients known to boost our overall health, helps our body with detoxification and overall health.
Terrain Theory
"The primary cause of disease is in us, always in us" Antoine Bechamp
"The blood is a flowing tissue and therefore spontaneously alterable"
Influenced by diet, lifestyle, emotions, environmental toxins, EMFs. These factors can alter the state of the blood and therefore the tissue, organs and whole body.
The body is always working to keep you in balance. When the body gets out of balance, a positive response will be that cells will release toxic matter (viruses), and pleomorphic organisms such as bacteria, fungal forms and yeast (candida) will appear as the clean up crew. Symptoms will ensue until the work is complete. This is called detoxification. Some call it flu. If we have underlying health conditions, then the symptoms of our own detox can actually cause fatal outcomes if our immune system is low and unable to assist the clean up crew, this is especially so for elderly people.
If our cells are lacking energy and vitality, a detox may not ensue. Toxic cells that do not self-destruct (apoptosis) or old cells that do not naturally degradate (autothagy) can eventually over time cause disease and cancer .
Work to keep the body clean by supporting a healthy terrain and immune system by following a more alkaline diet (applying the core principles) and good oxygen intake, and by avoiding poisons such as excess alcohol, caffeine, sugar, processed foods (highly acidic) and trans / processed fats. Watch stress levels and negative thoughts. They also play a role. Charge up the cells with daily grounding and/or the use of ionic foot baths.
Caroline Mansfield